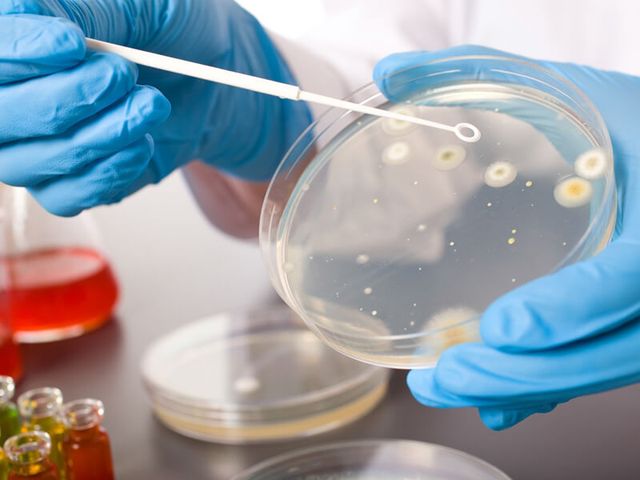
image

Уреаплазма — микроорганизм, вызывающий заболевания мочеполовой системы у женщин. Многие могут быть носителями уреаплазмы без симптомов, но инфекция иногда проявляется неприятными признаками и может привести к серьезным осложнениям. В статье рассмотрим основные симптомы и причины уреаплазмоза, а также эффективные методы лечения. Понимание проблемы поможет женщинам вовремя обратиться к врачу и избежать негативных последствий для здоровья.
Что такое уреаплазмоз?
Уреаплазмоз в настоящее время широко распространен и считается одной из самых распространенных инфекций, передающихся половым путем. Часто это заболевание встречается в сочетании с микоплазмозом. Кроме того, уреаплазмоз и трихомониаз также нередко сосуществуют в организме, вызывая поражения различных органов и систем.
В классификации болезней по МКБ 10 уреаплазмоз не включен в перечень заболеваний, передающихся через половые контакты. Тем не менее, уреаплазмоз (10 МКБ) упоминается в контексте таких заболеваний, как вагинит, уретрит и цервицит.
Эксперты в области гинекологии подчеркивают, что уреаплазма является одним из распространенных микроорганизмов, обитающих в организме женщин. Симптомы инфекции могут варьироваться от бессимптомного течения до выраженных проявлений, таких как жжение, зуд и выделения из влагалища. Основными причинами возникновения инфекции являются незащищенные половые контакты, а также ослабленный иммунитет. Важно отметить, что уреаплазма может привести к серьезным осложнениям, включая воспалительные заболевания органов малого таза. Лечение обычно включает антибиотики, однако выбор препарата должен основываться на результатах лабораторных исследований. Специалисты рекомендуют регулярные обследования и профилактические меры для предотвращения инфекции.

Опасность уреаплазмоза
Прежде всего, стоит сказать о том, что активная деятельность бактерий ureaplasma способна вызвать развитие серьезных заболеваний мочевыводящих органов. Это цистит (воспаление мочевого пузыря), пиелонефрит (воспаление почечных лоханок), уролитиаз (мочекаменная болезнь). Из-за ферментативной активности уреаплазмы она может приводить к поражениям тканей суставов (артритам).
У мужчин результатом уреаплазмоза может стать орхоэпидимит (воспаление придатка яичка), половая дисфункция или бесплодие (астеноспермия), поскольку наличие в сперме Ureaplasma parvum или Ureaplasma species вызывает нарушение структуры сперматозоидов.
У женщин активное размножение бактерий уреаплазма парма или уралитикум может вызвать:
- воспаление слизистых оболочек влагалища или матки (кольпит, цервицит, эндометрит);
- эрозия шейки матки;
- воспаление мышечных тканей матки (миометрит);
- маточные спайки;
- замирание беременности;
- выкидыш (самоаборт) или преждевременные роды.
Хотя считается, что ureaplasma не оказывает тератогенного действия на плод, то есть не вызывает у него пороков развития, она может вызывать инфицирование амниотической жидкости, став причиной фетоплацентарной недостаточности, при которой кислород и питательные вещества поступают к находящемуся в утробе матери ребенку в недостаточном количестве.
Кроме всего прочего, опасность уреаплазменной инфекции в сто, что она служит мощным фактором падения иммунитета. А организм с ослабленной иммунной системой легко поддается воздействию других инфекционных агентов, начиная с вируса гриппа и заканчивая возбудителем СПИДа.
| Аспект | Описание | Важные замечания |
|---|---|---|
| Что такое уреаплазма? | Уреаплазма – это условно-патогенный микроорганизм, который относится к классу микоплазм. Он может обитать на слизистых оболочках мочеполовой системы человека, не вызывая симптомов. | Уреаплазма не является классической бактерией или вирусом, а занимает промежуточное положение. |
| Причины возникновения | 1. Половой путь передачи: основной путь заражения, особенно при незащищенных половых контактах. 2. Вертикальный путь: от матери к ребенку во время беременности или родов. 3. Снижение иммунитета: стресс, хронические заболевания, переохлаждение, гормональные нарушения. 4. Нарушение микрофлоры влагалища: дисбактериоз, частые спринцевания. |
Не всегда наличие уреаплазмы приводит к заболеванию. Важен баланс микрофлоры и состояние иммунитета. |
| Симптомы у женщин | 1. Выделения из влагалища: обычно прозрачные или беловатые, могут быть скудными, иногда с неприятным запахом. 2. Зуд и жжение: в области наружных половых органов. 3. Дискомфорт при мочеиспускании: частые позывы, жжение. 4. Боли внизу живота: тянущие, ноющие, усиливающиеся при половом акте. 5. Боли при половом акте (диспареуния). 6. Бесплодие или невынашивание беременности: в запущенных случаях. |
Симптомы могут быть неспецифичными или отсутствовать вовсе. Часто уреаплазма обнаруживается случайно при обследовании. |
| Диагностика | 1. ПЦР-диагностика: выявление ДНК уреаплазмы в мазках из влагалища, цервикального канала или мочи. 2. Бактериологический посев: определение количества уреаплазм и их чувствительности к антибиотикам. 3. ИФА (иммуноферментный анализ): выявление антител к уреаплазме в крови (менее информативен для диагностики активной инфекции). |
Диагностика должна проводиться квалифицированным специалистом. Самодиагностика и самолечение недопустимы. |
| Лечение | 1. Антибиотикотерапия: препараты из группы макролидов, тетрациклинов или фторхинолонов. Выбор препарата и дозировки индивидуален. 2. Иммуномодулирующая терапия: для укрепления иммунитета. 3. Местное лечение: свечи, вагинальные таблетки для восстановления микрофлоры. 4. Лечение сопутствующих заболеваний: дисбактериоз, воспалительные процессы. |
Лечение должно быть комплексным и назначаться врачом. Обязательно лечение полового партнера. Контроль излеченности после терапии. |
| Осложнения | 1. Воспалительные заболевания органов малого таза: эндометрит, сальпингоофорит. 2. Бесплодие. 3. Невынашивание беременности, преждевременные роды. 4. Осложнения во время беременности и родов. 5. Уретрит, цистит. |
Своевременное лечение позволяет избежать большинства осложнений. |
| Профилактика | 1. Защищенный секс: использование презервативов. 2. Регулярные обследования: особенно при смене половых партнеров. 3. Укрепление иммунитета: здоровый образ жизни, правильное питание, отказ от вредных привычек. 4. Соблюдение правил личной гигиены. |
Важно помнить, что уреаплазма может быть частью нормальной микрофлоры, но при определенных условиях становится патогенной. |
Интересные факты
Вот несколько интересных фактов о уреаплазме у женщин:
-
Скрытая инфекция: Уреаплазма может присутствовать в организме без явных симптомов. Многие женщины не подозревают о наличии инфекции, так как она может не вызывать никаких клинических проявлений. Это делает диагностику сложной и требует регулярного медицинского обследования.
-
Связь с другими заболеваниями: Уреаплазма может быть связана с развитием различных гинекологических заболеваний, таких как бактериальный вагиноз, воспалительные заболевания органов малого таза и даже бесплодие. Это подчеркивает важность своевременной диагностики и лечения.
-
Лечение антибиотиками: Уреаплазма чувствительна к определенным антибиотикам, однако выбор препарата должен основываться на результатах лабораторных исследований. Самолечение может привести к развитию резистентности и ухудшению состояния, поэтому важно обращаться к врачу для назначения адекватной терапии.

Осложнения уреаплазмоза
У мужчин уретрит может привести к различным осложнениям, таким как баланопостит — воспаление головки и крайней плоти полового члена. Также возможны такие состояния, как простатит, а реже — эпидидимоорхит и шеечный цистит. При этом уреаплазмы не считаются отдельным возбудителем, способствующим воспалению предстательной железы. Вероятно, данная цепочка осложнений возникает через задний уретрит и осуществляется благодаря уретропростатическому рефлюксу, то есть забросу содержимого задней уретры в ацинусы простаты и семявыносящие протоки.
У женщин воспалительные заболевания органов малого таза могут осложняться образованием тубоовариального абсцесса, а в редких случаях могут развиться перитонит и сепсис. В отдалённой перспективе возможны серьёзные последствия, имеющие социальные последствия, такие как хроническая тазовая боль, внематочная беременность и бесплодие.
С малой вероятностью лишь наличие уреаплазм во влагалищной микрофлоре приведёт к таким осложнениям. Их патогенные свойства проявляются в сочетании с другими микроорганизмами, вызывающими дисбиотические изменения, такие как бактериальный вагиноз.
Причины возникновения болезни
Основные микроорганизмы, которые проникают в мочеполовую систему человека и зарождают очаг болезни — Уреаплазма Уреалитикум и Уреаплазма парвум.
Уреаплазма как заболевание, что это?
Это одноклеточные условно-патогенные бактерии. Так как они изначально являются элементами микрофлоры женщины. Из-за чего инфекция может очень много времени присутствовать в организме, но не быть причиной болезни. Но при создании необходимых условий, в данном случае негативных для здоровья человека, бактерии принимают активную форму развития и начинают говорить о себе признаками болезни.
Что может спровоцировать болезнь:
- цистит, воспаление мочевого пузыря
- заражение другими инфекциями, полученными при половом контакте
- половой контакт с партнером, у которого есть воспалительные процессы
- плохая гигиена в области половых органов
- воспалительные процессы органов малого таза

Кто является возбудителем уреаплазмоза?
Способы заражения
Существует несколько путей приобретения Уреаплазменной инфекции:
- во время полового контакта (более половины случаев)
- внутриутробно, во время вынашивания плода и через родовые пути при разрешении беременности
- бытовым путем в среде обитания человека более 30% случаев.
Способствуют передаче инфекции и условные факторы:
- начало половой жизни в раннем возрасте
- отсутствие предохранения во время половых контактов
- беспорядочные половые связи
- большое количество стрессовых ситуаций
- облучающие процедуры
- плохие условия проживания
- наличие хронических заболеваний
Еще одним важным моментом, способствующим заражению инфекцией, является слабый иммунитет. Возникнуть снижение иммунитета может из-за постоянных простудных заболеваний, плохого питания, неправильного образа жизни, нервного истощения и т.д.
Уреаплазмоз: пути заражения (половой контакт)
Это наиболее распространенный способ передачи инфекции. При незащищенном половом акте уреаплазма проникает на слизистую половых органов здорового человека. Что происходит далее? Возможны два сценария:
- После инкубационного периода (время от заражения до появления симптомов) начинают проявляться признаки заболевания. У женщин в первую очередь воспаляется слизистая влагалища, что называется кольпитом. У мужчин воспаление затрагивает либо уретру, либо мочеиспускательный канал, что известно как уретрит. Обычно инкубационный период составляет три-четыре недели, однако в зависимости от различных факторов он может как сокращаться, так и удлиняться.
- Уреаплазма может обосноваться на половых органах здорового человека, но при этом не проявляться никакими симптомами. Это состояние называется носительством уреаплазматической инфекции. Если инфекция обнаруживается у обоих партнеров, лечение не требуется.
Тем не менее, при определенных условиях уреаплазма на слизистых половых органов может спровоцировать развитие и активное проявление заболевания. К таким условиям относятся значительное ослабление иммунной системы и повреждение целостности слизистых оболочек репродуктивных органов.
Снижение иммунитета часто происходит на фоне простудных заболеваний, перенесенных острых инфекций, стрессов и интенсивных эмоциональных или физических нагрузок. Повреждение целостности половых органов может быть вызвано различными факторами, такими как хирургические вмешательства или наличие сопутствующих заболеваний, что открывает путь для инфекции. Уреаплазмоз часто встречается в сочетании с такими заболеваниями, как гонорея, хламидиоз и трихомониаз. Кроме того, бактериальный вагиноз, представляющий собой дисбактериоз во влагалище, может способствовать развитию уреаплазмоза у женщин.
Какие виды сексуальных контактов могут привести к передаче уреаплазмоза от инфицированного человека к здоровому? Возможно ли заражение уреаплазмозом орально?
На самом деле, не только традиционный и анальный секс могут привести к заражению уреаплазмозом. Уреаплазмоз также передается через оральный секс, после чего симптомы инфекции могут проявляться в виде признаков, схожих с ангиной. В таких случаях человек зачастую не подозревает о наличии у себя уреаплазмоза.
Таким образом, ответ на вопрос «передается ли уреаплазмоз через оральный секс» будет однозначно положительным, хотя такой способ передачи встречается реже, чем при традиционном половом акте. Оральное заражение уреаплазмозом опасно, так как инфекция может распространяться по всему организму из области рта.
Уреаплазмоз: как можно заразиться? (передача от матери к ребенку)
Уреаплазмоз, способы заражения которым не так многочисленны, может передаться и от инфицированной матери к ребенку.
Во время беременности плод довольно надежно защищен от проникновения к нему разнообразных инфекций. Однако, такая защита не срабатывает не всегда. Уреаплазма способна проникать к плоду через его оболочки из маточной полости (такой путь иначе называется восходящим путем передачи инфекции), или с кровотоком через кровеносные сосуды, которые поставляют плоду питательные вещества и кислород для нормального развития.
Если инфекция проникает в организм плода восходящим путем, происходит серьезное поражение его дыхательной системы. Часто возможно воспаление легких. Кроме такого поражения, могут наблюдаться многочисленные пороки развития различных органов и систем малыша.
Кроме опасности для плода, уреаплазмы могут наносить вред и самой женщине. Во время протекания беременности происходит стойкое снижение защитных сил организма и этот фактор способен спровоцировать запуск серьезного и сложнотекущего воспалительного процесса.
То есть уреаплазмы представляют угрозу во время беременности. Если такая инфекция была обнаружена на этапе планирования зачатия, необходимо провести лечение обоих будущих родителей, чтобы свести риск заражения плода к минимуму.
Имеются ли иные способы передачи уреаплазмоза?
Вопрос о бытовом способе передачи данной половой инфекции вызывает сомнения у медиков и ученых. Тем не менее, существует вероятность инфицирования, если, к примеру, человек использует влажное полотенце, которое ранее использовал больной уреаплазмозом. Бактерии предпочитают влажную среду для своего существования, что делает такую ситуацию потенциально опасной и способной увеличить риск заражения здорового человека. Таким образом, заражение уреаплазмозом в бане или бассейне теоретически возможно.
Также стоит отметить, что существует вероятность передачи инфекции во время трансплантации органов и тканей. Однако эту вероятность можно свести к минимуму благодаря тщательному обследованию доноров.
Учитывая все вышесказанное, важно помнить, что все перечисленные пути передачи уреаплазмоза остаются теоретически возможными. Поэтому необходимо принимать конкретные меры профилактики. При подозрении на наличие такой инфекции в организме следует незамедлительно обратиться к специалисту, который проведет необходимую диагностику.
Механизм развития инфекции
Главная способность микроорганизма – легкое преодоление мембранной защиты клеток и сцепление с их поверхностью. Именно таким образом она попадает в мочеполовую систему, цепляясь за слизистую эпителия и проникая в цитоплазматическую жидкость. Далее происходит продуцирование фермента, растворяющего иммуноглобулин А и происходит размножение. По этой причине иммунитет женщины падает и не способен защитить организм от атаки агентов.
При низкой активности патогена протекает практически бессимптомно. При высокой из-за повышения проницаемости тканей проявляется симптоматика, разрушаются клетки эпителий.
Инкубационный период уреаплазмоза
Уреаплазмоз: каков инкубационный период у мужчин? При обсуждении инкубационного периода важно понимать, что он может варьироваться у разных людей из-за индивидуальных особенностей организма. У мужчин этот период зависит от типа бактерий, которые попали в организм, а также от состояния иммунной системы. Если заражение произошло от инфицированной матери во время беременности, инкубационный период может длиться несколько лет. В случае полового заражения, инкубационный период составляет от двух дней до нескольких месяцев.
Что касается женщин, то средняя продолжительность инкубационного периода уреаплазмоза составляет около одного месяца. Однако это также зависит от состояния их иммунной системы. Уреаплазма у женщин может не проявлять никаких симптомов до тех пор, пока не произойдет сбой в балансе между нормальной микрофлорой и патогенными микроорганизмами. Если девочка заразилась от матери, она может долгое время не подозревать о наличии инфекции. Обнаружить ее можно только при сдаче анализов во время профилактических осмотров.
Классификация и стадии развития уреаплазмоза
По длительности протекания различают острый и хронический уретрит. Острый уретрит — до 2 месяцев, хронический — более 2 месяцев. В последнем случае различают рецидивирующий и персистирующий уретрит.
Хроническим рецидивирующим уретритом считается заболевание, при котором лейкоциты в уретре к концу лечения пришли в норму, а через 3 месяца — вновь наблюдался их подъём свыше 5 в поле зрения (при увеличении х1000). Хронический персистирующий уретрит — когда повышенное содержание лейкоцитов наблюдалось к концу лечения и через 3 месяца. [11]
ВЗОМТ подразумевает вовлечение в процесс маточных труб, яичника и их связок. Воспаление придатков может быть одно- и двухсторонним, острым или хроническим. Основные симптомы: боль внизу живота, в пояснице, выделения из половых органов, температура 38˚С и выше. [12]
Уреалитикум
Легко проникает в эпителиальные ткани слизистой оболочки половых органов и представляет собой серьезную угрозу для заражения.
При нормальном состоянии иммунной системы заболевание, скорее всего, не будет прогрессировать, поскольку вид уреалитикум не способен подавлять антитела. Он разрушает клетки крови и семенной жидкости.
Этот вид может вызывать образование спаек, непроходимость фаллопиевых труб, а также повышает риск бесплодия и внематочной беременности.
Уреаплазма Парвум
Уреаплазмоз обитает на слизистой влагалища у женщин. И с помощью фермента уреазы расщепляет мочевину и формируется аммиак. При размножении возникает воспалительный процесс в половых органах.
- Высока вероятность формирования камней в мочевыводящих каналах.
- Угнетаются защитные свойства организма за счет выработки антител к иммунитету.
Зачастую данный вид инфекции активируется при наличии таких недугов, как гонорея, хламидиоз. Инкубационный период парвум – до 4-х недель.
Уреаплазма Специес
Как и упомянутые ранее биовары, этот микроорганизм является частью нормальной микрофлоры, а его место обитания — мембрана половых клеток. Разрушая эти клетки, он вызывает воспалительные процессы. Чаще всего подвержены заражению мужчины.
Для эффективного и быстрого лечения заболевания важно точно определить вид микроорганизма с помощью специализированных исследований. Уреалитикум можно выявить только при значительном увеличении его численности. Парвум и Специес становятся заметными в ходе лабораторных анализов после завершения инкубационного периода.
Носители уреаплазмоза
Одна из самых распространенных бактерий уреаплазма может годами не обнаруживаться и мирно обитать в теле, отлично свыкаясь с микрофлорой. Именно по этой причине паразиты относятся к условно-патогенным. Опасность грозит только при создании условий – падении иммунитета, стрессов и других. А до этого момента женщина является носителем инфекции.
Важно: некоторые врачи при обнаружении микроорганизма тут же назначают терапию, в которой нет никакой необходимости. Их наличие еще не означает активную фазу болезни.
Согласно статистике до 80% населения может быть носителем паразитического уреаплазмоза и не подозревать об этом. Поэтому нужно понимать, что высок риск инфицирования или передачи сексуальному партнеру.
Проявления уреаплазмоза
Как уже упоминалось, основным проявлением уреаплазмоза являются воспалительные процессы в мочеполовой системе.
У мужчин симптомы уреаплазмоза могут проявляться в виде незначительных, мутных выделений из уретры, а также вялотекущего уретрита, который сопровождается жжением и зудом в области мочеиспускательного канала, а также умеренной болезненностью во время мочеиспускания. При этом выделения могут появляться и исчезать.
У женщин наблюдаются выделения из влагалища, которые могут сопровождаться болями внизу живота, зудом и раздражением слизистой влагалища. Реже возникают частые и болезненные позывы к мочеиспусканию, а также цервицит.
Если не проводить своевременное и адекватное лечение, а также пытаться заниматься самолечением, заболевание может перейти в хроническую стадию. Это ухудшает общее состояние организма, может привести к повышению температуры и стать причиной таких заболеваний, как простатит, кольпит, эндометрит, цистит, пиелонефрит, везикулит, воспаление придатков матки, образование спаек в маточных трубах, что может вызвать самопроизвольные аборты и преждевременные роды.
Хроническая инфекция со временем может привести к стриктуре уретры, то есть сужению мочеиспускательного канала.
Одним из наиболее серьезных последствий уреаплазмоза является астеноспермия — форма мужского бесплодия. Возбудитель уреаплазмоза снижает подвижность сперматозоидов, паразитируя на них и уменьшая их жизнеспособность. Кроме того, уреаплазма может негативно влиять на здоровье суставов, вызывая их воспаление.
Без лечения уреаплазмоз может проявляться периодически. Повторные обострения часто связаны с чрезмерным употреблением алкоголя, простудами или эмоциональными перегрузками.
Первые признаки уреаплазмоза у женщин
У многих женщин сегодня симптомы могут и не показываться, то есть болезнь протекает в скрытой форме. У них нет болей, из влагалища не наблюдается никаких выделений, а также не регистрируются изменения и сбои менструального цикла. Однако если у женщины снижается иммунитет или она заболевает чем-то, этот бессимптомный период заканчивается.
Уреаплазмоз у женщин, симптомы и причины которого не полностью установлены, по своим признакам и проявлениям может напоминать и другие болезни.
Уреаплазмоз: симптомы у женщин (фото) – такой запрос помогает посмотреть на патологию и определить, как же на самом деле она выглядит. Если женщина подозревает у себя какие-либо проявления этой болезни, необходимо срочно обратиться к доктору для подтверждения или опровержения диагноза.
Уреаплазмоз у женщин (причины возникновения и симптомы) проявляется так:
- Симптоматика ангины. В этом случае появляется налет на миндалинах в виде гноя, горло начинает сильно болеть. Кроме того, нужно отметить, что этот признак характерен для заражения, наступившего орально-генитальным путем;
- Влагалищные выделения. Они в основном не имеют ни запаха, ни цвета. Если выделения принимают желто-зеленый или желтоватый оттенок, это свидетельствует о начале воспалительного процесса в женском организме;
- Постоянные позыв в туалет. В данном случае также отмечается боль и чувство жжения при мочеиспускании;
- Боли и дискомфорт во влагалище во время занятий сексом;
- Режущие боли в нижней части живота. Это может говорить о протекании интенсивного воспаления в матке и ее придатках.
Хронический уреаплазмоз у женщин: симптомы и лечение, причины – что можно сказать об этом? При переходе в хроническую стадию уреаплазмоз затрагивает слизистые репродуктивных органов, что ведет к интенсивному размножению уреаплазм, поскольку именно такая среда благоприятна для них. Обострение уреуплазмоза будет наблюдаться тогда, когда организм подвергается заболеваниям иного рода, чрезмерным физическим перегрузкам, стрессам и влиянию других негативных факторов.
Уреаплазма во время беременности
Если говорить о плановом зачатии, то перед тем, как забеременеть, женщина должна пройти полное медицинское обследование. В случае выявления Уреаплазмы во время этого обследования, назначается лечение. Зачатие разрешается только после завершения курса терапии и повторной диагностики.
Однако бывают ситуации, когда женщина могла заразиться инфекцией до беременности, не подозревая об этом. Это связано с тем, что Уреаплазма может проявляться слабо выраженными симптомами. В результате, болезнь может быть обнаружена только во время беременности. Также существует риск заражения во время самой беременности в процессе полового акта.
Все внутриутробные инфекции, включая Уреаплазму, представляют собой серьезную угрозу для беременности. Инфекция, попадая к плоду, может вызвать различные негативные последствия. У новорожденного могут развиться воспалительные заболевания глаз и горла, аллергические реакции, кожные проблемы и другие осложнения.
Кроме того, острое течение инфекции может привести к преждевременным родам, замершей беременности или недоразвитию плода. Поэтому к Уреаплазме следует относиться с особой осторожностью.
В связи с этим, врачи назначают лечение Уреаплазмы даже во время беременности. Все препараты подбираются с учетом состояния плода, чтобы не причинить ему вреда.
Однако полноценное лечение до рождения ребенка невозможно, поэтому повторный курс терапии назначается после родов, когда женщина завершит период лактации. После рождения малыша проводится повторное обследование на наличие инфекции.
По этой причине женщинам, планирующим зачатие, рекомендуется сдавать анализы на урогенитальные инфекции. В противном случае, наличие болезни во время беременности может привести к серьезным последствиям для здоровья ребенка.
Диагностика
При подозрении на уреаплазмоз проводится комплекс диагностических мероприятий, Методы диагностики выбирает врач. Они могут включать исследование образцов крови, мочи, соскобов с поверхности влагалища или уретры, эякулята или секрета простаты. В настоящее время используется несколько методик качественного и количественного определения reaplasma.
ПЦР (молекулярно-биологический метод полимеразной цепной реакции)
Для анализа берут мазки из уретры или половых органов, а также мочу или сперму. Метод ПЦР позволяет выявить бактерии рода ureaplasma, а также определить их количество и вид. Результаты анализа можно получить всего через 5 часов, а точность метода достигает почти 100%.
Если ПЦР-тест показывает наличие Ureaplasma parvum или Ureaplasma urealyticum в крови или слизистых оболочках пациента, врач обязательно назначит дополнительные исследования на наличие других инфекций, передающихся половым путем. Уреаплазмоз часто сопровождается такими заболеваниями, как герпес, гонорея, хламидиоз и трихомоноз.
ИФА (иммуноферментный анализ)
Это исследование крови с помощью тест-систем, которое позволяет выявить не саму бактерию, а выработанные на нее антитела. Данный способ диагностики не считается полностью достоверным, поскольку иммунный ответ на инфекцию не всегда имеет место, а антитела могут быть обнаружены после излечения заболевания. Кроме того, метод не позволяет дифференцировать Ureaplasma urealyticum от Ureaplasma parvum.
РИФ
Данный метод представляет собой экспресс-диагностику, предназначенную для тестирования антигенов и антител, и основывается на принципе флюоресценции. Прямой метод (РПИФ) дает возможность выявить микробы, в то время как непрямой метод иммунофлюоресценции используется для идентификации комплекса антиген–антитело.
Серологический анализ на уреаплазмоз
Такой метод сегодня редко применяется ввиду его невысокой точности. Однако иногда доктор может направить пациента именно на такое исследование.
Если лечащий и наблюдающий пациента доктор выбирает тот или иной вариант сдачи анализа на уреаплазмоз, это обусловлено какими-либо причинами. Доктору лучше знать, на что именно направить пациента. Верная диагностика с высокой точностью и чувствительностью позволит вовремя начать лечить уреаплазмоз, чтобы избежать проявления его осложнений.
Культуральная диагностика
Метод заключается в посеве биологического материала на питательную среду. Если в образцах, таких как мазок, моча или секрет простаты, присутствуют уреаплазмы, они начинают активно размножаться, расщепляя мочевину. В результате этого процесса изменяется цвет индикатора pH, который был добавлен в питательную среду.
Согласно рекомендациям Министерства здравоохранения России, диагноз «уреаплазмоз» устанавливается при обнаружении в крови или мазках из уретры или влагалища бактерий Ureaplasma в количестве ≥ 104 КОЕ/мл, а также при наличии признаков воспалительного процесса. В международной классификации болезней (МКБ 10) уреаплазмоз относится к группе «Бактериальная инфекция неуточненной локализации» и имеет код A49.3, а также обозначение «Инфекция, вызванная микоплазмой, неуточненная».
На видео врач-дерматовенеролог подробно объясняет современные методы диагностики уреаплазмоза.
Как подготовиться к обследованию?
Перед посещением врача необходимо придерживаться таких советов:
- Исключить половые акты за пару суток до посещения врача;
- Не мочиться за несколько часов до похода к врачу;
- Подмывание с мылом должно происходить вечером накануне исследования, с утра делать этого не нужно;
- Не использовать накануне вагинальные спреи, мази и крема, а также внутривлагалищные таблетки;
- Отказаться от спринцеваний.
Данные рекомендации главным образом актуальны для проведения процедуры забора мазка из половых органов пациента.
Лечение уреаплазмоза у женщин
Ключевым аспектом при выявлении бактерий является необходимость лечения обоих половых партнеров.
Во время беременности лечение заболевания обязательно, независимо от ситуации. Выбор методов и препаратов зависит от срока беременности и индивидуальных особенностей терапии. Если возникают риски прерывания беременности или обострения хронических заболеваний, лечение проводится только при наличии осложнений. При стабильном состоянии беременной женщины терапия осуществляется на 30-й неделе для устранения инфекции в родовых путях.
Антибиотики
Наиболее эффективным средством при лечении являются препараты антибиотического ряда. Применяются три группы:
- макролиды:
- тетрациклины;
- фторхинолоны.
Какой из препаратов выбирать – решает лечащий врач, основываясь на показаниях исследований, общей картине заболевания, состояния иммунной и других систем пациента. В любом случае, существуют правила, которые следует соблюдать:
- Лечиться должны оба партнера.
- Категорически нельзя вносить самостоятельные поправки в схему терапии.
- Не допускается прерывание лечения, необходим комплексный и полный курс.
Важно: врачи рекомендуют ограничить половые контакты, но лучше исключить их на время лечения полностью.
В некоторых случаях показано применение сразу двух видов препаратов, но только при наличии сопутствующих инфекционных патологий. Курс лечения зависит от выбранного лекарства:
- кларитромицин – одна-две недели;
- доксициклин – до 10 дней;
- эритромицин — до одной недели;
- аминогликозиды – до 10 дней;
- азитромицин (1 грамм) – однократный прием.
Наиболее эффективными считаются антибиотики полусинтетического типа – группа тетрациклинов.
Лечение может вызвать побочные эффекты:
- головокружение;
- головную боль;
- тошнота;
- рвота;
- рези в животе;
- диарею.
Применение любых лекарственных форм может стать причиной аллергической реакции, проявляющейся через:
- сыпь;
- покраснение и отек кожи;
- зуд;
- кашель;
- чихание, насморк;
- отек Квинке, анафилактический шок.
Все перечисленные моменты могут быть угрозой для жизни, по этой причине важно определить, есть ли аллергия на те или иные наименования.
Пробиотики
Применение антибиотиков приводит к уничтожению не только вредоносных бактерий, но и полезной микрофлоры. Тем не менее, без этих препаратов невозможно справиться с инфекцией. Для восстановления нормальной микрофлоры необходимо использовать пробиотики и пребиотики. В состав таких средств, как Апилак, Лактобактерин, Бифидумбактерин и Лактусан, входят полезные микроорганизмы. Они доступны в различных формах, включая сиропы и свечи.
Иммунотерапия
В виду того, что микроорганизм способен размножаться при падении уровня иммунитета, важной составляющей лечения является ее повышение. Назначаются иммуностимуляторы и иммуномодуляторы типа:
- неовир;
- иммуномакс;
- циклоферон и др.
Препараты выпускается в форме сиропа, таблеток, инъекций. Также применяются свечи Виферон, обладающие отличным эффектом и прекрасной сочетаемостью с другими лекарствами.
Вагинальные свечи
При уреаплазмозе у пациента наблюдается снижение иммунной защиты, что приводит к возникновению вторичных заболеваний, таких как молочница, микоплазмоз и хламидиоз. Слизистая оболочка влагалища подвергается воспалению, на стенках появляются микротрещины. Для эффективной борьбы с инфекциями в терапию добавляются антисептические и противовоспалительные средства в форме вагинальных свечей.
Вагинальные свечи Гексикон
В аптеках предлагается два вида препарата: Гексикон и Гкексикон Д. Отличие в дозировке основного действующего компонента. Свечи используются в схеме лечения уреаплазмоза и в качестве профилактического средства. Препарат подходит беременным женщинам, так как имеет минимум противопоказаний.
Гексикон воздействует на микроорганизмы, останавливая их развитие и размножение. Обладает противовоспалительным действием и снижает риски для ребенка столкнуться с инфекцией во время родового процесса.
Уничтожить паразита Гексикон не сможет, так как часть инфекции останется в крови женщины. После родов рекомендуется повторное лечение антибиотиками.
Схема приема: Одна свеча в сутки, вводится перед сном. Курс составляет 10–14 дней. Если воспалительный процесс в острой форме, то назначается введение свечи два раза в день.
При применении свечей у пациентки могут проявиться побочные симптомы: зуд и жжение во влагалище. Неприятные симптомы проходят после отмены препарата.
Вагинальные пилюли Тержинан
Таблетки Тержинан обладают многофункциональным действием: они антибактериальные, противовоспалительные и антигрибковые. Главным активным компонентом препарата является неомицин. Он эффективно уничтожает микроорганизмы, что позволяет избавиться от инфекции уже после первого курса лечения.
Тержинан представляет собой препарат нового поколения, который бережно воздействует на микрофлору влагалища. Он предотвращает развитие грибков рода Кандида, ответственных за возникновение молочницы.
Таблетку следует вводить во влагалище один раз в сутки, предпочтительно перед сном. Рекомендуемый курс лечения составляет 10 дней, однако, если уреаплазма проникла глубже в мочеполовую систему, может потребоваться увеличение курса до 15 дней.
Применение Тержинана запрещено для девушек младше 16 лет и для беременных женщин в первые три месяца беременности. В то же время, во втором и третьем триместрах использование вагинальных таблеток не является противопоказанием.
Во время лечения могут возникать зуд и жжение в области слизистой влагалища, однако эти симптомы исчезают после завершения курса.
Капсулы Полижинакс
Комплексный препарат Полижинакс является эффективным противомикробным, противовоспалительным и противогрибковым средством. Препарат снимает зуд и жжение, оказывает заживляющее действие. Слизистая быстро восстанавливается, и больного перестают беспокоить основные симптомы уреаплазмоза.
Воздействие Полижинакса на плод полностью не изучено, поэтому на втором и третьем триместре беременности свечи назначаются, но только под наблюдением врача. Первые три месяца применение препарата противопоказано.
Курс приема 12 дней по одной свечке на ночь. Если по каким-то причинам курс прерывается, то лечение начинается сначала.
Во время приема наблюдаются побочные действия:
- Жжение в области влагалища,
- Эритема,
- Зуд половых органов.
Симптоматика не является причиной к отмене препарата и исчезает после окончания курса лечения.
Свечи Виферон и Генферон
Иммуномодуляторы играют важную роль в быстром восстановлении организма и активизации его защитных сил в борьбе с инфекциями. Среди эффективных иммуностимуляторов можно выделить вагинальные свечи Виферон и его аналог Генферон.
Эти препараты действуют на клетки, восстанавливая их защитные функции. Свечи отличаются отсутствием побочных эффектов и оказывают мягкое воздействие на женский организм.
Виферон можно использовать начиная с третьей недели беременности. Обычно курс лечения составляет около 10 дней, однако схема применения подбирается индивидуально для каждой женщины.
Полиоксидоний
При диагностике запущенной стадии заболевания больному назначается Полиоксидоний. Препарат выпускается в трех формах: таблетированный, ампулами для инъекций и в виде вагинальных свечей. Стандартно при уреаплазмозе медикамент выписывается в виде свечей.
Препарат производится на основе лактозы, поэтому противопоказан больным с индивидуальной непереносимостью этого компонента и беременным. Запрещено применение во время кормления грудью и при патологии почек.
Стандартная схема приема: по одной свече на ночь в течение трех дней, затем перерыв два дня. На шестые сутки опять вводиться одна свеча. Затем делается отдых на два дня. Опять вводиться свеча. Курс продлевается на усмотрения специалиста.
Побочных действий у Полиоксидония не выявлено.
В комплексе со свечами назначаются мази с антимикробным и заживляющим эффектам: тетрациклиновая и эритмауиновая. Мази наносятся на половые органы каждый день в течение 12–15 суток.
Препараты для восстановления микрофлоры слизистой
Поскольку лечение инфекций невозможно без использования антибиотиков, важно восстановить не только слизистую мочеполовой системы, но и желудочно-кишечного тракта.
Для восстановления слизистой оболочки ЖКТ рекомендуется использовать следующие препараты:
- Препараты с лактобактериями: Линекс, Лактобактерин, Хилак-Форте
- Препараты с бифидобактериями: Бифидумбактерин в порошках, Бификол, Бифиформ
Все эти средства содержат живые полезные бактерии, которые необходимы для восстановления нормальной флоры ЖКТ. Их следует принимать 1–2 раза в день до еды. Эффективность лактобактерий возрастает, если препарат запивать молоком.
Полезные микроорганизмы также присутствуют в натуральных продуктах, таких как йогурт, бифидок, тан и айран.
После завершения основной противомикробной терапии рекомендуется использовать препараты для восстановления флоры влагалища: Лактожиналь, Лактонорм, Лактагель. Эти средства содержат живые лактобактерии, поэтому их необходимо хранить в холодильнике при температуре +4 градуса.
Курс приема препаратов для восстановления микрофлоры ЖКТ и слизистой мочеполовой системы составляет 3–4 недели. В более сложных случаях может быть назначена схема приема на срок до полугода.
Физиотерапевтические процедуры
Важная роль в комплексном подходе отводится применению физиотерапевтических процедур, предназначенные для устранения осложнений и усиления иммунитета:
- Массаж для устранения спаек в трубах.
- Лечение грязью для терапии и профилактики воспалительных процессов.
- Гирудотерапия. Метод позволяет устранить спаечный процесс, снять воспаление и повысить иммунитет.
- Облучение крови (внутривенно). Усиливает иммунитет, устраняет воспаление.
- Электрофорез. Отличный способ истреблять колонии патогенной флоры.
- Озонотерапия. Внутривенно вводятся препараты, в состав которых входит озон, что активизирует защитные функции человеческого организма.
- Магнитотерапия. Метод активирует циркуляцию крови, открывает доступ кислорода к мельчайшим капиллярам, улучшает защитные силы организма и устраняет воспаления.
Существует еще масса физиотерапевтических видов воздействия на бактерию, весьма эффективных в комплексном лечении. Определиться с выбором и количеством сеансов должен только специалист – гинеколог.
Народные методы лечения
Домашние средства могут значительно облегчить и ускорить процесс лечения уреаплазмоза. К таким средствам относятся настои и отвары из лекарственных растений, которые способствуют укреплению иммунной системы, а также продукты, богатые фитонцидами — биоактивными веществами, способствующими подавлению роста патогенных бактерий.
Одним из самых известных природных антимикробных и иммуностимулирующих средств является чеснок. Рекомендуется употреблять его в сыром виде, по 2-3 зубчика ежедневно. Чеснок эффективно уменьшает воспаление и выступает в роли мощного природного антибиотика. Также полезен отвар или холодный настой травы золотарника.
Можно применять и многокомпонентные травяные смеси. Для этого растения, взятые в равных пропорциях (примерно по столовой ложке), измельчают, заливают стаканом кипятка и настаивают около 12 часов. После этого настой процеживают и принимают по 1/3 стакана перед приемом пищи.
Смесь №1
- семена укропа;
- корень первоцвета;
- цветы медуницы;
- листья крапивы, малины, березы и подорожника.
Смесь №2
- цветы зверобоя, клевера и трехцветной фиалки;
- корень аира;
- семена и листья подорожника;
- трава полыни.
Смесь №3
- цветки череды и аптечной ромашки;
- корни левзеи, копеечника и солодки;
- шишки ольхи.
Терапия хронического уреаплазмоза
При осложненной или хронической форме уроплазмоза антибиотикотерапия может быть более длительной, включая одновременный или последовательный прием нескольких препаратов. Для повышения иммунитета могут быть назначены натуральные или синтетические иммуномодуляторы: Иммунал, Иммунтил, настойки эхинацеи, лимонника, зверобоя, а также витамины.
В некоторых случаях для купирования симптомов заболевания, устранения воспаления, профилактики осложнений прибегают к использованию физиотерапевтических процедур или средств местного воздействия:
- инстилляции лекарственных веществ в мочеиспускательный канал, орошения влагалища, ректальные суппозитории;
- массажу предстательной железы у мужчин или гинекологическому массажу у женщин;
- гирудотерапии;
- внутривенному облучению крови лазером (ВЛОК).
Лечение уреаплазмоза у беременных имеет свои особенности. Даже малое количество бактерий в мочеполовом тракте представляет опасность, ведь иммунитет женщины в период вынашивания ребенка значительно снижается, это физиологическое явление. Поэтому обследоваться на предмет наличия патогенной микрофлоры рекомендуется еще при планировании беременности. Но если случилось так, что уреаплазма обнаружена уже в период беременности, будущей маме назначают препараты, позволяющие подавить размножение бактерии.
Поскольку очень многие антибиотики в период беременности запрещены, самый безопасный из них подберет акушер-гинеколог, учитывая состояние пациентки, разновидность инфекции и сроки беременности. Принимать препарат нужно будет под постоянным медицинским контролем. При возможности лечение уреаплазмоза проводят со 2 триместра, тогда у ребенка уже сформированы внутренние органы, поэтому риск развития внутриутробной патологии минимален.
Терапия острого уреаплазмоза
При неосложненной острой форме заболевания основными средствами терапии являются антибиотики, чаще всего назначаются макролиды:
- Эритромицин. Рекомендуется принимать в течение 1-2 недель по 500 мг четыре раза в день.
- Азитромицин (Хемомицин, Сумамед). Схема приема: в первый день 500 мг однократно, затем по 250 мг в течение следующих четырех дней.
- Кларитромицин. Дозировка — 250 мг дважды в день на протяжении 1-2 недель.
- Рокситромицин. Рекомендуется принимать по 150 мг дважды в день, курс лечения составляет 10 дней.
К побочным эффектам этих препаратов относятся расстройства со стороны желудочно-кишечного тракта: боли и дискомфорт в животе, тошнота, диарея. Противопоказаниями являются гиперчувствительность к макролидам, серьезные заболевания печени и сердечно-сосудистой системы, а также беременность и период грудного вскармливания.
Помимо макролидов, также применяется полусинтетический антибиотик из группы тетрациклинов — Доксициклин. Стандартная схема приема составляет 100 мг дважды в день на протяжении 10 дней. Побочные эффекты возникают редко и аналогичны таковым у макролидов. Доксициклин следует использовать с осторожностью при печеночной недостаточности, лейкопении и порфирии. Беременным и кормящим женщинам применение Доксициклина противопоказано.
Особенности терапии во время беременности
Если уреаплазмоз протекал без видимой симптоматики, то женщина не сдавала анализы и не беспокоилась о лечении до зачатия ребенка. При диагностике заболевания во время беременности, необходима немедленная терапия. Во время родов инфекция передаетсяребенку, а на ранних сроках беременности микроорганизм является провокатором выкидышей и замирания развития.
Терапия беременных требует особого внимания, так как большая часть препаратов противопоказана и может нанести вред малышу. Схема лечения подбирается тщательно и этапами.
Если болезнь на начальном этапе, то врач старается обойтись без антибиотиков. В качестве основного препарата используются вагинальные антибактериальные и противогрибковые свечи. Важно убрать уреаплазмы из слизистой влагалища, чтобы защитить малыша. В крови женщины микроорганизм сохранится, поэтому после родов приступают к основному лечению.
Если без антибиотиков не обойтись, то выбирается самая безопасная их группа — макролиды. Терапия начинается с 20 или 22 недели беременности и имеет продолжительность 3 недели. В сложных случаях лечение начинается с 16 недели беременности, но эта схема опасна для малыша.
Схема терапии для беременных включает в себя прием препаратов:
- Антибиотика: Эрацин, Клабакс, Макропен,
- Противогрибковый препарат: Пимафуцин в виде вагинальных свечей,
- Иммуностимуляторы на натуральной основе: Настойка Эхинацеи,
- Иммуномодулирующие свечи: Виферон.
Раз в день проводиться санация влагалища любым мягким антисептическим раствором. Промывание поможет освободить слизистую от пагубных микроорганизмов.
В комплексе с лечением назначаются поливитамины: Элевит Пронаталь, Компливит Мама или любые для беременных.
Основная задача терапии во время беременности — освободить от инфекции родовые пути. Уничтожить уреаплазму можно после родов.
Как выявить произошло ли излечение?
Профилактика заболевания
Правильно приняв меры, можно не допустить заражение такой инфекционной болезнью, как Уреаплазма.
Ниже приведены основные способы профилактики:
- Посещение гинеколога или уролога 1 раз в шесть месяцев
- Раз в год, при наличии активной половой жизни, сдавать анализы на диагностику урогенитальных инфекций
- Избегать переохлаждения органов малого таза
- Пропивать сезонно витаминный комплекс
- Тщательно следить за гигиеной половых органов
- Заниматься сексом с использованием презерватива
- После незащищенного полового акта обрабатывать поверхность половых органов раствором Хлоргексидина или Мирамистина
- Регулярно менять нательное и постельное белье
- Не пользоваться предметами чужой личной гигиены
- после посещения сауны, бассейна и водоемов общего пользования провести дезинфекцию половых органов специальными средствами
- не вступать в половые контакты с малознакомыми партнерами
- Не пользоваться чужими полотенцами, постельным бельем и одеждой
- Своевременно лечить воспалительные процессы органов мочеполовой системы
- Интересоваться состоянием здоровья полового партнера
- Сбалансировано питаться, избегая жирной и острой пищи
Перед принятием решения о зачатии ребенка, посетить гинеколога и рекомендовать партнеру так же пройти обследование у уролога.
Всегда нужно помнить, вовремя диагностированная болезнь не обретет сложных форм и будет иметь минимальное воздействие на организм. Нужно бережно относиться к собственному здоровью, выполняя все рекомендации и предписания врачей.
Вести здоровый образ жизни, не ухудшая самостоятельно условия жизни. Следить за качеством своей личной жизни, не подвергая опасности здоровье, за счет случайных половых связей.
Правильная гигиена половых органов у мужчин и женщин
Мужчины и женщины должны постоянно заботиться о гигиене половых органов. Это важное правило поможет предотвратить возникновение заболеваний и других негативных последствий. Для обеспечения безопасности рекомендуется принимать душ дважды в день, уделяя особое внимание тщательной очистке интимных зон. Важно своевременно лечить вагиноз и кандидоз, если они возникают. При уреаплазмозе рекомендуется использовать антисептики, назначенные врачом, для поддержания гигиены.
Следуя здоровому образу жизни и указанным рекомендациям, можно значительно снизить риск появления патогенных бактерий в организме. Врачи рекомендуют заниматься спортом, например, посещать тренажерный зал или бегать, чтобы укрепить общее состояние здоровья.
Вывод
На период лечения партнерам необходимо соблюдать правила:
- Воздержание от половой жизни на период лечения антибиотиками (на восстановительном этапе половую жизнь можно возобновить, но только с использованием презерватива),
- Из рациона исключаются жирные, сладкие, кислые и острые блюда, чтобы не раздражать слизистую ЖКТ,
- На протяжении всей терапии недопустимо употребление спиртосодержащих напитков,
- Придерживаться гигиенических норм.
Лечение уреаплазмы , это сложный и многоэтапный процесс. Не стоит заниматься самолечением. Схема и виды препаратов назначаются специалистом после проведения ряда обследований и изучения полного анамнеза.
При соблюдении правил и правильно подобранной терапии, справиться с инфекцией можно без последствий для здоровья.
Рекомендации по образу жизни и питанию при уреаплазмозе
Уреаплазмоз — это инфекционное заболевание, вызванное бактериями рода Ureaplasma, которые могут обитать в организме человека, особенно в мочеполовой системе. Для успешного лечения и предотвращения рецидивов важно не только следовать медицинским рекомендациям, но и обратить внимание на образ жизни и питание.
1. Соблюдение гигиенических норм: Важно поддерживать высокие стандарты личной гигиены. Регулярное мытье половых органов с использованием мягких, неагрессивных средств поможет предотвратить размножение патогенных микроорганизмов. Также стоит избегать использования общих полотенец и предметов личной гигиены.
2. Правильное питание: Сбалансированное питание играет ключевую роль в поддержании иммунной системы. Включите в рацион больше свежих фруктов и овощей, богатых витаминами и антиоксидантами. Особенно полезны продукты, содержащие витамин C (цитрусовые, киви, ягоды), а также продукты, богатые цинком (орехи, семена, морепродукты), которые способствуют укреплению иммунитета.
3. Увлажнение организма: Питьевой режим также важен. Употребление достаточного количества воды помогает выводить токсины и поддерживать нормальную работу мочеполовой системы. Рекомендуется пить не менее 1,5-2 литров воды в день, если нет противопоказаний.
4. Избегание стрессов: Стресс может негативно сказаться на иммунной системе, поэтому важно находить способы для его снижения. Это могут быть занятия спортом, медитация, йога или просто прогулки на свежем воздухе. Поддержание психоэмоционального равновесия способствует улучшению общего состояния организма.
5. Ограничение алкоголя и отказ от курения: Алкоголь и табак негативно влияют на иммунитет и могут способствовать развитию различных инфекций. Ограничение или полный отказ от этих привычек поможет организму быстрее восстановиться и снизить риск рецидивов.
6. Регулярная физическая активность: Умеренные физические нагрузки способствуют улучшению кровообращения и укреплению иммунной системы. Рекомендуется заниматься физической активностью не менее 150 минут в неделю, выбирая те виды спорта, которые приносят удовольствие.
7. Регулярные медицинские осмотры: Важно проходить регулярные медицинские осмотры и консультации у гинеколога. Это поможет своевременно выявить возможные проблемы и предотвратить развитие осложнений.
Следуя этим рекомендациям, можно значительно улучшить общее состояние здоровья и снизить риск рецидивов уреаплазмоза. Однако важно помнить, что любые изменения в образе жизни и питании должны обсуждаться с врачом, особенно в случае наличия хронических заболеваний или других медицинских показаний.
Вопрос-ответ
Как вылечить уреаплазму раз и навсегда?
Полностью вылечить болезнь нельзя. Уреаплазмоз – одна из самых распространенных болезней, которая передается половым путем и поражает органы мочеполовой системы. Возбудителями данного заболевания считаются бактерии Ureaplasma urealyticus из семейства Micoplasmataceae.
Как лечится уреаплазма у женщин?
В отношении уреаплазм наибольшей активностью обладают антибиотики группы макролиды или тетрациклины. Уреаплазмоз относится к инфекции, которая передается половым путем. При этом заболевание не считается венерологическим. Терапия уреаплазмоза является длительной и требует точного выполнения врачебных назначений.
Советы
СОВЕТ №1
Регулярно проходите медицинские обследования. Уреаплазма может не проявляться ярко выраженными симптомами, поэтому важно регулярно посещать гинеколога для профилактических осмотров и анализов.
СОВЕТ №2
Обратите внимание на симптомы. Если вы заметили изменения в менструальном цикле, болезненные ощущения внизу живота или необычные выделения, не откладывайте визит к врачу. Ранняя диагностика поможет избежать осложнений.
СОВЕТ №3
Соблюдайте правила личной гигиены. Поддержание чистоты и здоровья половых органов может снизить риск инфекций, включая уреаплазму. Используйте средства для интимной гигиены, избегайте синтетического нижнего белья и старайтесь не переохлаждаться.
СОВЕТ №4
Не занимайтесь самолечением. Если у вас есть подозрения на уреаплазму, не пытайтесь лечиться самостоятельно. Обратитесь к врачу для получения точного диагноза и назначения адекватного лечения.